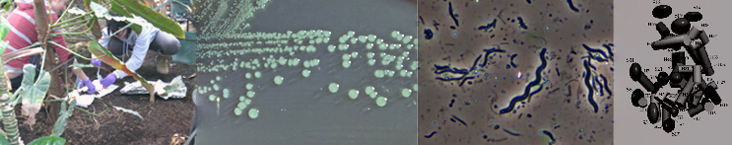

BISC209/F13
Welcome to Microbiology LAB Fall 2013
Laboratory Instructors: Tucker Crum and Janet McDonough
Lab Prep: Sherly Veeraragavan
Labs: L302- Tues. 12:30-4 Instructor Crum; Wed. 2:15-5:45 Instructor McDonough
GOALS: The labs for BISC 209, Microbiology, are designed to familiarize you with how research investigation in microbiology is designed, performed, analyzed, and communicated. Over the course of the semester, you will explore the richness and diversity of environmental microbes and explore their impact in their community. Your instructor does not know what's in the specimen you will collect; therefore, the successful outcome of the project is in your hands alone. You will learn to work as a microbiologist, to perform the experiments properly, to keep good records of your results, and to articulate the findings and conclusions from your work, both orally and in written reports.
One of the focuses of the lab component of BISC209 is learning how microbiologists communicate their findings to the scientific community. You will end the semester by writing a scientific style research paper on a semester long project.
These are ambitious goals for an introductory microbiology course. Since this course only has one prerequisite, BISC110/112, we expect that some of you will come into the course with extensive experience in cellular biology and research investigation, while others will have had little related experience or course work. Our main goal is for everyone to end the course equally comfortable and facile with the tools and techniques of investigative microbiology and to understand how to write about your findings.
GENERAL LABORATORY DIRECTIVES
1. Please familiarize yourself in advance with the exercise(s) to be performed. Read each exercise and any accompanying technical material carefully.
2. Record accurate and detailed descriptions of your investigation and your results following the guidelines for maintaining a lab notebook provided in Resources.
3. Your instructor will give preliminary instructions and/or demonstrations at the beginning of each lab. Do not attempt to start work before receiving instructions. Please make sure that you understand the purpose and execution of each part of the investigation and ask any clarifying questions before getting to work.
POLICY ON LATE ASSIGNMENTS, LAB MAKE-UP, AND RECEIVING CREDIT FOR LAB:
Make up of laboratory work in another lab section is not possible.
All late assignments must be submitted within a week. All late work is subject to a penalty of 5% per day late and is not accepted for point credit after one week. Although lab assignments contribute only 1/3 of the points for your course grade (200 out of 600), you MUST pass (acquire at least 60% of the total possible lab points) to receive course credit.
Good luck